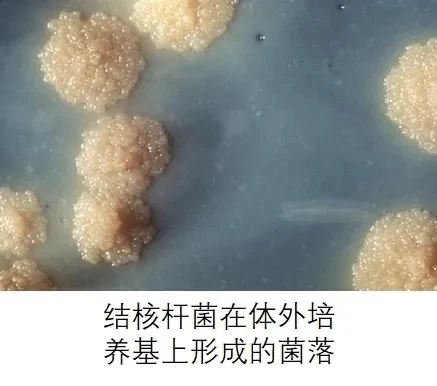
image.

海因⾥希·赫尔曼·罗伯特·科赫( Heinrich Hermann Robert Koch 1843.12.11-1910.5.27),德国医师兼微⽣物学家,为细菌学始祖之⼀,与路易•巴斯德、费迪南德•科恩共享盛名。
科赫因发现炭疽杆菌、结核杆菌和霍乱弧菌⽽出名,并且提出⼀套⽤于鉴别病原微⽣物的依据——科赫法则。1905年,他因研究结核病⽽获得诺⻉尔⽣理学或医学奖。德国医学的最⾼奖项——罗伯特•科赫奖就是以他的名字命名。

早年
科赫出⽣在德国⼩城克劳斯塔尔,7岁那年,科赫家乡的⼀位牧师去世,科赫在去参加葬礼的路上不断问着⺟亲牧师得了什么病,⽽⺟亲却⽆法回答他,这在年幼的科赫⼼中埋下了从医的种⼦。
1862年,19岁的科赫以极为优异的科学以及数学成绩进⼊格丁根⼤学学习,3个学期后,科赫转向学习医学,1866年1⽉以优秀的成绩从医学院毕业。

研究炭疽杆菌
1870年,普法战争爆发,27岁的科赫⾃愿报名参军,在沃尔什滕⼩镇担任区域医疗官。当时,炭疽病在他的驻扎地中⼴为流⾏。
炭疽病是⼀种⼈畜共患的急性传染病,由炭疽杆菌所致,⼈会因接触病畜及其产品及⻝⽤病畜的⾁类⽽发⽣感染。临床上主要表现为⽪肤坏死、溃疡、焦痂和周围组织⼴泛⽔肿及毒⾎症症状,⽪下及浆膜下结缔组织出⾎性浸润;⾎液凝固不良,呈煤焦油样,偶可引致肺、肠和脑膜的急性感染,并可伴发败⾎症。

其病原体炭疽杆菌为⼀种需氧或兼性厌氧型有芽孢的⾰兰阳性细菌,繁殖体抵抗⼒不强,易被⼀般消毒剂杀灭,但它们的芽孢对恶劣环境具有极强的抵抗⼒,在⼲燥的室温环境下甚⾄可以存活数⼗年之久。
其实,早在1850年,法国医师卡⻄⽶尔•达⻙纳等⼈就已经成功分离出了炭疽杆菌,但并未证实这就是造成炭疽病的元凶。在达⻙纳发表炭疽病在⽜与⽜之间可直接传染的现象之后,科赫更加仔细地研究这个疾病。他发现,由于这种病原体⽆法⻓时间在宿主体外存活,炭疽病原就会形成⼀种抵抗⼒极强的内孢⼦,即芽孢。⽽这些存于⼟壤⾥的内孢⼦就是造成过去⽆法解释的炭疽病⼤流⾏的罪魁祸⾸。这⼀发现同时也是⼈类⾸次发现微⽣物能够致病的事实。
研究结核杆菌
1880年,科赫被任命为德国皇家卫⽣署的⼀员,专⻔研究传染性疾病的病因和管控⽅法。
当时,每7⼈中就有⼀⼈死于结核病,⽽在中古世纪的欧洲,结核病更是造成了三分之⼀以上⼈⼝死亡的可怕传染病。
今天,我们知道结核杆菌是结核病的病原体。这是⼀种转性需氧型的细菌,抗酸染⾊阳性,⽆鞭⽑,有菌⽑,有微荚膜但不形成芽孢,其细菌壁既没有⾰兰阳性菌的磷壁酸,也没有⾰兰阴性菌的脂多糖,可经呼吸道、消化道、⽪肤损伤侵⼊⼈体,引起多种组织器官的结核病,并以肺部结核最为多⻅。
⽽在科技并不发达的19世纪,⼈们普遍认为结核病是⼀种遗传性的疾病,但科赫则坚信这是⼀种有某种细菌引起的传染性疾病,于是他⾸先将⼯作的重点放在了研究结核病和寻找结核病的病原体上,并于1882年3⽉24⽇发现了结核杆菌,为结核病的防治做出了⽆可⽐拟的巨⼤贡献。
科赫法则
除了对病原菌的研究,科赫还于1890年提出了⽤于建⽴疾病和微⽣物之间的因果关系的理论公式,也就是著名的的“科赫法则”。
科赫法则主要分为四个步骤:
病体罹病部位经常可以找到⼤量的病原体,⽽在健康活体中找不到这些病原体。
病原菌可被分离并在培养基中进⾏培养,并记录各项特征。
纯粹培养的病原菌应该接种⾄与病株相同品种的健康植株,并产⽣与病株相同的病征。
从接种的病株上以相同的分离⽅法应能再分离出病原,且其特征与由原病株分离者应完全相同。
这套重要的理论思维对后世有着深远的影响,帮助许多疾病研究确认了病原体。
晚年
⾃1885年起,科赫在柏林弗⾥德⾥希•威廉⼤学担任教授,1891年成为普鲁⼠传染病研究院院⻓,1904年退休以后开始环游世界,并在世界各地开展更多的传染病研究。
1905年,为表彰他为结核病研究作出的重⼤贡献,斯德哥尔摩卡罗琳医学院授予科赫“诺⻉尔⽣理学或医学奖”这⼀⾄⾼荣誉。

1910年5⽉27⽇,66岁的科赫因⼼肌梗塞于德国巴登去世。为纪念这位伟⼤的病原微⽣物学家,德国专⻔设⽴“罗伯特•科赫奖”,甚⾄在⽇本京都的北⾥⼤学内还建有专⻔供奉他的神社。
(部分图片来源于网络,如有侵权请联系删除)